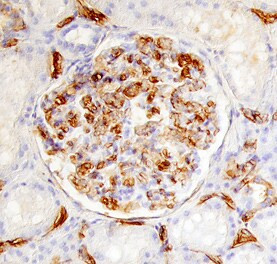
IL17RD Antibody in Immunohistochemistry (Paraffin) (IHC (P))

Search
Invitrogen
IL17RD Polyclonal Antibody
{{$productOrderCtrl.translations['antibody.pdp.commerceCard.promotion.promotions']}}
{{$productOrderCtrl.translations['antibody.pdp.commerceCard.promotion.viewpromo']}}
{{$productOrderCtrl.translations['antibody.pdp.commerceCard.promotion.promocode']}}: {{promo.promoCode}} {{promo.promoTitle}} {{promo.promoDescription}}. {{$productOrderCtrl.translations['antibody.pdp.commerceCard.promotion.learnmore']}}
图: 1 / 2
IL17RD Antibody (PA5-47287) in IHC (P)


产品信息
PA5-47287
种属反应
宿主/亚型
分类
类型
抗原
偶联物
形式
浓度
规格
纯化类型
保存液
内含物
保存条件
运输条件
RRID
产品详细信息
In direct ELISAs, approximately 40% cross-reactivity with recombinant mouse (rm) IL-17 RD is observed and less than 10% cross-reactivity with recombinant human (rh) IL-17 RC, rmIL-17B R, and rhIL-17 R is observed.
Reconstitute at 0.2 mg/mL in sterile PBS.
靶标信息
Feedback inhibitor of fibroblast growth factor mediated Ras-MAPK signaling and ERK activation. May inhibit FGF-induced FGFR1 tyrosine phosphorylation. Regulates the nuclear ERK signaling pathway by spatially blocking nuclear translocation of activated ERK without inhibiting cytoplasmic phosphorylation of ERK. Mediates JNK activation and may be involved in apoptosis. Might have a role in the early stages of fate specification of GnRH-secreting neurons.
仅用于科研。不用于诊断过程。未经明确授权不得转售。
篇参考文献 (0)
生物信息学
蛋白别名: cytokine receptor; hSef; IL-17 receptor D; IL17Rhom; Interleukin-17 receptor D; Interleukin-17 receptor-like protein; Sef homolog; similar expression to fgf genes; unnamed protein product
基因别名: HH18; IL-17RD; IL17RD; IL17RLM; SEF; UNQ6115/PRO20026
UniProt ID: (Human) Q8NFM7
Entrez Gene ID: (Human) 54756